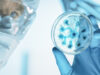
Mort suspecte d’un enfant liée à la bactérie E.coli

WHAT'S NEW
Les fortes chaleurs ralentissent notre cerveau
Plusieurs études affirment qu’il est normal que le cerveau fonctionne “au ralenti” durant les fortes ...
ACCESSORIES
Application Tous Anti-Covid : marchera, marchera pas ?
Le gouvernement mise sur la nouvelle application « Tous Anti Covid » pour tracer davantage les personnes ...
Pesticide dangereux dans du riz Taureau Ailé
Le riz basmati complet de Taureau Ailé est rappelé depuis le 23 janvier. Il contient un pesticide interdit, connu ...
WINDOWS PHONE
Nos astuces pour une randonnée réussi en toute sécurité
En pleine saison estivale, la montagne nous appelle pour nous ressourcer. Attention toutefois car la randonnée ...
Derniers articles
Une révolution médicale : un implant oculaire redonne la vue à 80 % des malades de la DMLA
Une nouvelle avancée pourrait changer la vie de millions de personnes atteintes de DMLA sévère. Des chercheurs ont développé un implant oculaire sous-rétinien, conçu pour restaurer une vision centrale chez les seniors victimes de cette maladie dégénérative. Une étude publiée en octobre 2025 dans le New England Journal of Medicine montre que plus de 80 % des patients opérés...
Top Santé 2025 : ces innovations qui vont changer votre santé et votre alimentation
Les lauréats des Prix Top Santé 2025 Le palmarès des Prix Top Santé 2025 a été dévoilé, mettant en lumière des produits innovants dans plusieurs catégories. Catégorie Bien-être Le gagnant est Danone avec le Danacol à boire. Ce supplément, enrichi en stérols végétaux, aide à réduire le cholestérol, un facteur de risque pour les maladies cardiaques. Catégorie Bien Manger La pâte à tartiner Noisette...
Démence : ces signes physiques à ne pas ignorer pour agir vite
La démence, souvent reconnue par des troubles de la mémoire ou des changements de comportement, peut aussi présenter des signes physiques. Ces symptômes corporels, parfois subtils, doivent être pris au sérieux car ils peuvent indiquer une évolution de la maladie. En France, plus de 1,4 million de personnes vivent avec une forme de démence, notamment Alzheimer. Les experts soulignent...
Fêtes de Noël : une hausse alarmante des crises cardiaques à cause du stress et de l’excès
Une augmentation des crises cardiaques pendant les fêtes Les fêtes de fin d'année sont souvent synonymes de festins, d'alcool et de nuits courtes. Ce mode de vie peut mettre à rude épreuve le corps. Chez certaines personnes, cela peut entraîner ce qu'on appelle le "syndrome du cœur des vacances". Il s'agit d'une perturbation du rythme cardiaque, généralement causée par une...
Pourquoi vous vous réveillez épuisé malgré 8 heures de sommeil
Pourquoi certaines personnes se réveillent épuisées malgré 8 heures de sommeil Il est courant de penser que dormir huit heures par nuit suffit à assurer un repos réparateur. Pourtant, beaucoup de personnes se réveillent encore fatiguées, avec la sensation de ne pas avoir réellement récupéré. Il est important de savoir que la qualité du sommeil est tout aussi essentielle que...
Mauvaise haleine : découvrez la véritable cause et la solution surprenante
Qui n’a jamais souffert de mauvaise haleine ? Contrairement aux idées reçues, cette gêne ne provient pas uniquement d’un manque d’hygiène ou d’une routine de soins défaillante. Elle peut aussi résulter d’un déséquilibre du microbiote buccal ou de problèmes de gencives. Les solutions classiques comme les dentifrices, les brosses à dents ou les bains de bouche ne suffisent pas toujours....
Vivez plus longtemps : 14 ans d’espérance de vie en adoptant ces simples gestes
Une étude française montre qu'il est possible d'augmenter son espérance de vie jusqu'à 14 ans Selon une recherche publiée ce mercredi 17 décembre, vivre sans fumer, sans surpoids ni cholestérol pourrait permettre de gagner jusqu’à 14 ans d’espérance de vie. Cette étude s’est basée sur les données de plus de deux millions de personnes âgées de 18 ans et plus,...
1,7 Million d’Enfants exposés aux Pesticides près de leur École
Plus de 1,7 million d'élèves exposés à une forte pression pesticide près de leur école Selon un baromètre publié le jeudi 18 décembre, plus de 1,7 million d'élèves en métropole sont scolarisés à proximité d’établissements soumis à une forte pression de pesticides. Ces données, issues d'une cartographie inédite, montrent que ces élèves vivent dans un rayon de 1 000 mètres...
PMA : le diagnostic pré-implantatoire qui pourrait sauver des vies
De nombreux professionnels de la procréation médicalement assistée (PMA) en France réclament l'autorisation du diagnostic pré-implantatoire des aneuploïdies (DPI-A). Cette technique permet d’analyser les chromosomes des embryons avant leur implantation afin de détecter d’éventuelles anomalies chromosomiques, telles que la trisomie ou la monosomie. Ces anomalies sont une cause fréquente d’échec d’implantation et de fausses couches. Une question de souffrance et...
Attention danger : ce médicament couramment utilisé peut tuer en cas de rhume
Un médicament mortel en cas de rhume Le 18 décembre 2025, une nouvelle alerte sanitaire a été émise concernant un médicament couramment utilisé pour traiter la fièvre et la douleur. Selon les autorités de santé, ce médicament a été responsable de la mort de 12 personnes, dont des enfants et de jeunes adultes en bonne santé. Ce médicament, souvent pris en...